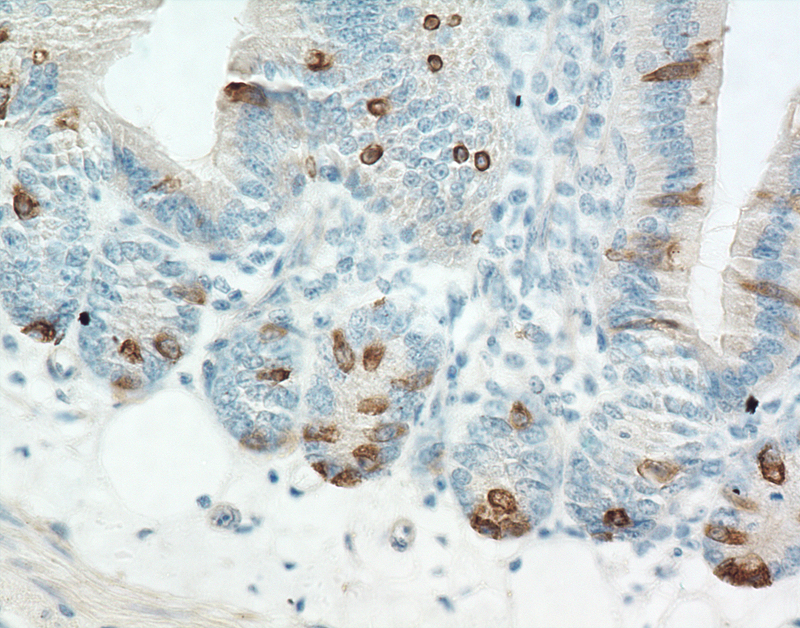

Pathology Image Detail
Caption |
Small intestine - Normal tissue. There is strong labeling for alpha-catenin of a small to moderate number of individual epithelial cells predominantly located in intestinal crypts and also scattered along intestinal villi. |
Description |
Small intestine - normal tissue. |
Age at Necropsy |
unknown |
Contributor |
Mikaelian I (J:94310) |
Pathologist |
Mikaelian I (J:94310) |
Method |
IHC for alpha catenin |
Type: antibody |
|
Model |
|
Strain |
|